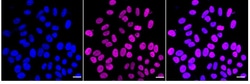
Invitrogen RbAp48 Recombinant Rabbit Monoclonal Antibody (24GB1240) 100

missing translation for 'onlineSavingsMsg'
Learn More
Learn More
Invitrogen™ RbAp48 Recombinant Rabbit Monoclonal Antibody (24GB1240)


Rabbit Recombinant Monoclonal Antibody
Brand: Invitrogen™ MA557680
This item is not returnable.
View return policy
Description
RbAp48 Recombinant Monoclonal Antibody for Western Blot, ICC/IF, Flow
RbAp48-11G10 recognizes full length RbAp48, a 48 kDa nuclear protein first isolated by its ability to interact with the carboxyl-terminus of the retinoblastoma protein (Rb). It is a member of the WD (Trp-Asp) repeat family of proteins. RbAp48 is one of the three subunits of CAF-1, can bind to histone H4 and is a subunit of human histone deacetylase HD1.
Specifications
| RbAp48 | |
| Recombinant Monoclonal | |
| Unconjugated | |
| RBBP4 | |
| CAF-1 p48 subunit; CAF-1 subunit C; CAF-I 48 kDa subunit; CAF-I p48; chromatin assembly factor 1 subunit C; Chromatin assembly factor I p48 subunit; chromatin assembly factor/CAF-1 p48 subunit; histone-binding protein RBBP4; lin-53; mRbAp48; MSI1 protein homolog; nucleosome-remodeling factor subunit RBAP48; NURF55; RB binding protein 4, chromatin remodeling factor; RBAP48; RBBP4; RBBP-4; retinoblastoma binding protein 4; retinoblastoma-binding protein 4; Retinoblastoma-binding protein p48 | |
| Rabbit | |
| Affinity chromatography | |
| RUO | |
| 19646, 313048, 5928 | |
| -20°C | |
| Liquid |
| Flow Cytometry, Western Blot, Immunocytochemistry | |
| 24GB1240 | |
| PBS with 50% glycerol and 0.02% sodium azide; pH 7.4 | |
| Q09028, Q60972 | |
| RBBP4 | |
| A synthesized peptide derived from human RbAp48 (aa 2-51). | |
| 100 μL | |
| Primary | |
| Human, Mouse, Rat | |
| Antibody | |
| IgG |
Product Content Correction
Your input is important to us. Please complete this form to provide feedback related to the content on this product.
Product Title
Spot an opportunity for improvement?Share a Content Correction